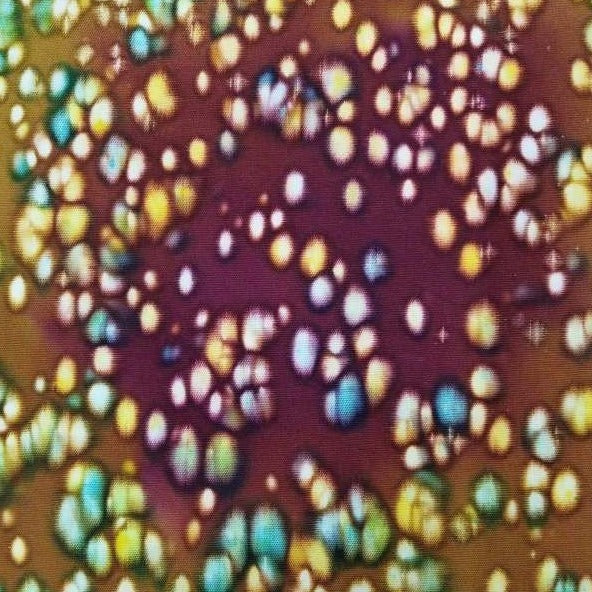

$6 AUD / 25cm = 1 unit
Sundaze
Sundaze
20 in stock
Couldn't load pickup availability
Remember a hazy Sunday? The batik reminds you just as that, and it is perfect for your next quilting or textile project. It is made of 100% cotton from Indonesia, and locally-made and sourced, making it a sustainable fabric. Each (1) unit order states the quantity of 0.25m, which means you'll need to add up the quantity to 4 to get 1m.
-
We are now a fully Indonesian company
As Jacky has relocated to Bali.
The charges shown are in AUD (or your local currency), but the final charges will be in IDR (Indonesian Rupiah).
Don't panic though, we've correctly adjusted the prices to our AUD benchmark. 😊 -
Cotton combed 40s
All Wacky Jacky's cotton and rayon batik are handstamped and handmade in a studio of Indonesian textile artisans. They won't fray under the needles, and your quilt will be machine washable (we've proven this!).
-
Difference in colours
Due to the nature of batik and other handmade fabrics, you'll find a slight difference in colour and design as each had been made uniquely by hand.
You may also like
-
Melanie Light Grey
Regular price $6.50 AUDRegular priceUnit price per -
Luscious Feather
Regular price $6.00 AUDRegular priceUnit price per -
Indigo Floral Arrows
Regular price $6.50 AUDRegular priceUnit price per